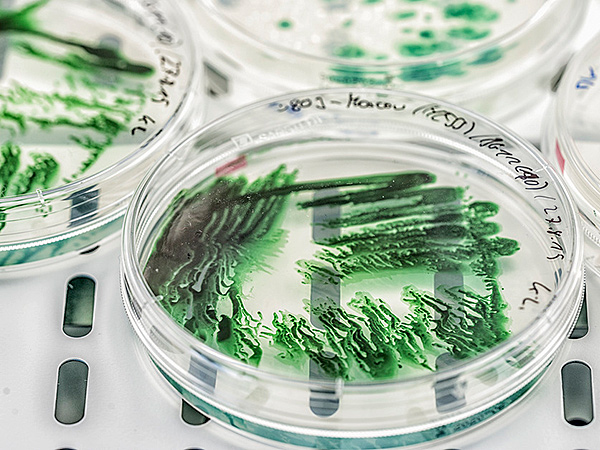
Kultur und Zucht von Cyanobakterien in Petri-Schalen. Foto: Andr&eacute; K&uuml;nzelmann /UFZ

Energy research at the UFZ
However, complex interactions between the natural and social environments also give rise to obstacles, conflicts of objectives and new types of environmental risks. The implementation of transformation in such a framework is a challenge that can only be overcome through the interaction of innovative technologies, comprehensive understanding of their effects, and further development of policy options and regulatory instruments. Accordingly, three types of research contributions are required:
- Technical innovations that enable a more environmentally sound energy supply and more energy-efficient production processes,
- Analysis of options for integrated provision of renewable energy within concrete environmental and living conditions,
- Development of regulatory and management approaches for reduction of energy use and sustainable energy provision based on renewable energy.
Renewable energies
 Quelle: André Künzelmann / UFZ
Quelle: André Künzelmann / UFZ
Subproject 1: Integrating Renewable Energies and Resources in Energy Landscapes
Carbon Dioxid Removal
 Quelle: Stefan Ouwenbroek - Fotolia
Quelle: Stefan Ouwenbroek - Fotolia
Subproject 2: Exploring Carbon Dioxid Removal (CDR) & Negative Emission Technologies in Transforming Energy Landscapes
Biotechnological processes
 Quelle: André Künzelmann / UFZ
Quelle: André Künzelmann / UFZ
Development of biotechnological processes of sustainable production of chemicals and energy sources
Photobiotechnology
Quelle: André Künzelmann / UFZ
Quelle: André Künzelmann / UFZ
Bioartificial photosynthesis for the production of hydrogen
Geotechnics
 Quelle: A. Künzelmann / UFZ
Quelle: A. Künzelmann / UFZ
Environmental geotechnologies contribute to the topic "Georesources – energy and raw materials for future societies " (Helmholtz Programme "Changing Earth - Sustaining our Future").
